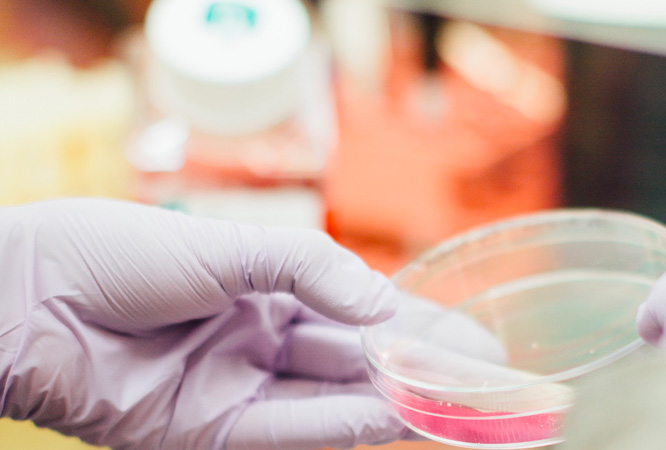

Bando Agenas: la Sardegna prima nel sud e terza in Italia con il progetto “A Kent’Annos in Salude”
Il modello sardo di presa in carico dei “Granzi Anziani”, attraverso percorsi integrati di prevenzione, assistenza domiciliare e telemedicina, vedrà protagoniste tutte le Aziende Sanitarie della regione